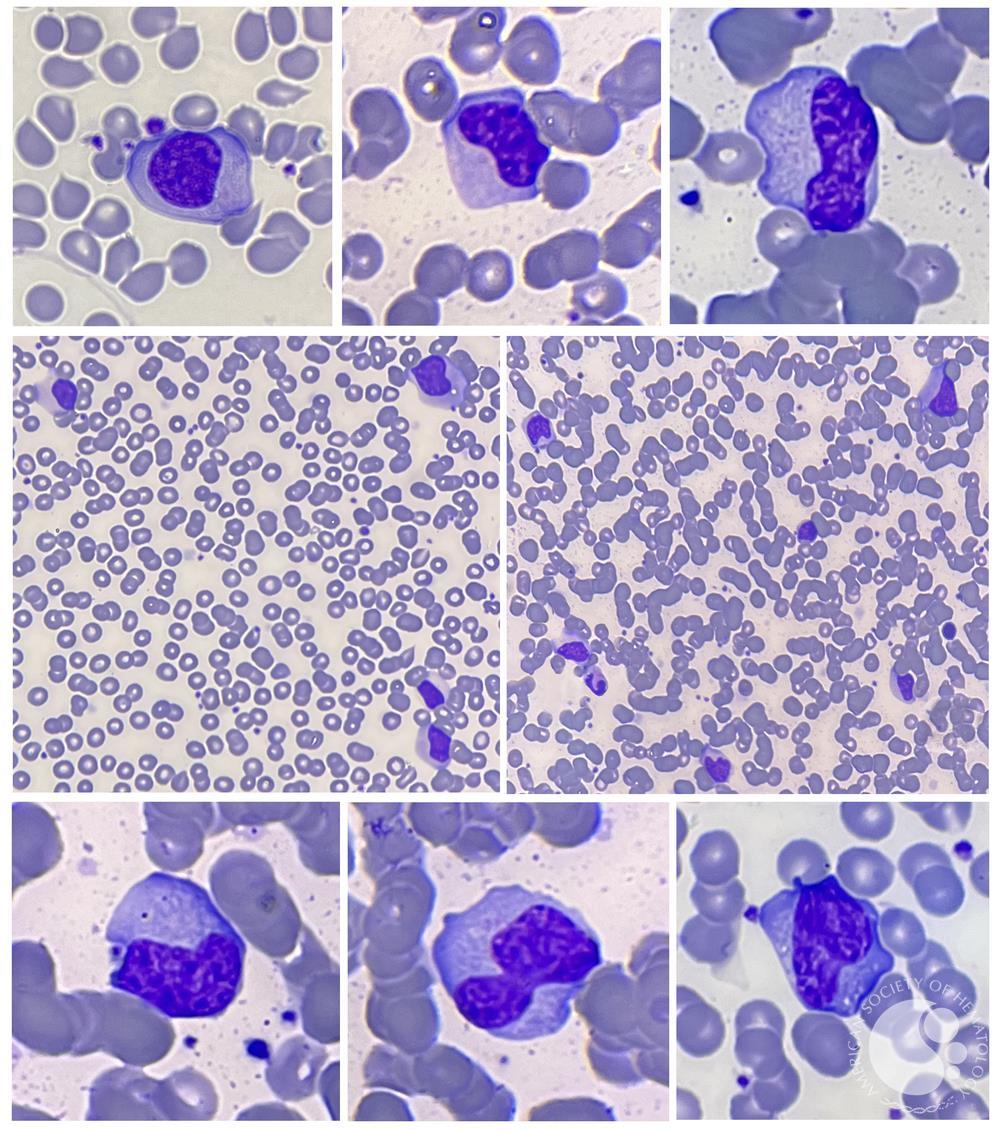
عفونت گلو شیراز متخصص اطفال

درباره نویسنده
مونونوکلئوز عفونی در بورد اطفال
سوالات مختلفی از این مبحث اورده می شود مهمترین انها را از نلسون 2025 می اوریم
مونونوکلئوز عفونی در بورد اطفال
ویروس اپشتین–بار (EBV) بیش از ۹۵٪ جمعیت جهان را آلوده میکند. انتقال آن عمدتاً از طریق ترشحات دهانی انجام میشود. در کودکان، انتقال میتواند با تبادل بزاق از کودک به کودک رخ دهد؛ مانند حالتی که بین کودکان در مهدکودکها/مراکز نگهداری کودک خارج از خانه اتفاق میافتد.
EBV پس از عفونت حاد،بیش از ۶ ماه بهطور مداوم در ترشحات دهانی دفع (shed) میشود و سپس بهصورت متناوب تا پایان عمر دفع میگردد. در هر زمان مشخص، تا حدود ۲۰–۳۰٪ افراد سالمِ آلوده به EBV ممکن است ویروس را دفع کنند.
EBV همچنین در ترشحات تناسلی مردان و زنان یافت میشود و برخی مطالعات احتمال انتقال از طریق تماس جنسی را مطرح کردهاند. در مقابل،تماسهای غیرصمیمانه، منابع محیطی و فومیتها (وسایل/سطوح آلوده) نقشی در انتقال EBV ندارند.
نکات مهم (برای جمعبندی سریع)
شیوع بسیار بالا: آلودهسازی > ۹۵٪ جمعیت جهان
راه اصلی انتقال:ترشحات دهانی / بزاق
کودکان: انتقال با تبادل بزاق (بهویژه در مهدکودک)
دفع ویروس:
>۶ ماه مداوم بعد از عفونت حاد
سپس متناوب تا آخر عمر
افراد سالم ناقل/دافع: در هر زمان ۲۰–۳۰٪ ممکن است ویروس را دفع کنند
انتقال جنسی: محتمل (به دلیل حضور در ترشحات تناسلی)
عدم نقش در انتقال:تماس غیرصمیمانه، محیط، فومیتها
اصطلاحات مهم (Glossary)
EBV (Epstein–Barr Virus): ویروس اپشتین–بار؛ از خانواده هرپسویروسها و بسیار شایع.
Transmission (انتقال): عبور عامل عفونی از فرد آلوده به فرد حساس.
Oral secretions (ترشحات دهانی): بزاق و ترشحات داخل دهان که میتوانند حامل ویروس باشند.
Saliva (بزاق): مایع دهان؛ مهمترین حامل EBV در انتقال کودک به کودک.
Out-of-home childcare (مراقبت/نگهداری کودک خارج از خانه): مهدکودک/خانه کودک؛ محیط پرریسک برای تبادل بزاق بین کودکان.
Acute infection (عفونت حاد): مرحله اولیه و فعال عفونت با علائم یا تکثیر بالاتر ویروس.
Viral shedding (دفع/ریزش ویروس): خروج ویروس از بدن (مثلاً در بزاق) که میتواند موجب انتقال شود.
Consistently (بهطور مداوم): دفع پیوسته در یک بازه زمانی (اینجا: بیش از ۶ ماه).
Intermittently (بهصورت متناوب): دفع گاهبهگاه و غیرپیوسته (اینجا: تا پایان عمر).
Genital secretions (ترشحات تناسلی): ترشحاتی که از دستگاه تناسلی مرد/زن خارج میشود و ممکن است حامل ویروس باشد.
Sexual contact (تماس جنسی): تماس جنسی بهعنوان مسیر احتمالی انتقال در برخی مطالعات.
Nonintimate contact (تماس غیرصمیمانه): تماسهای معمول روزمره (مثل دست دادن) که در این متن در انتقال EBV مؤثر دانسته نشدهاند.
Environmental sources (منابع محیطی): محیط (هوا/آب/فضا) بهعنوان منبع انتقال؛ در EBV نقش ندارد.
Fomites (فومیتها/اشیای آلوده): وسایل یا سطوحی که میتوانند عامل بیماریزا را منتقل کنند؛ در انتقال EBV نقشی ندارند.
تشخیص آزمایشگاهی (EBV / مونونوکلئوز عفونی) — ترجمه فارسی با نکات برجسته
1) شمارش سلولهای خونی (CBC) و اسمیر محیطی
بیشتر بیماران (>۹۰٪) دچار لکوسیتوز ۱۰٬۰۰۰ تا ۲۰٬۰۰۰ سلول/µL هستند که حداقل دوسوم آن لنفوسیت است.
لنفوسیتهای آتیپیک معمولاً ۲۰–۴۰٪ کل لکوسیتها را تشکیل میدهند.
این سلولهای آتیپیک در واقع لنفوسیتهای T بالغ هستند که بهصورت آنتیژنی فعال شدهاند.
ظاهر میکروسکوپی لنفوسیت آتیپیک نسبت به لنفوسیت معمولی:
درشتتر (بزرگتر از نظر اندازه کلی)
هسته بزرگتر با جایگاه اگزانتریک (خارج از مرکز)
هسته فرورفته/شیاردار و تاخورده (indented & folded)
نسبت هسته به سیتوپلاسم کمتر (nuclear-to-cytoplasm ratio پایینتر)
نکته: لنفوسیتوز آتیپیک در عفونتهای دیگر هم دیده میشود، اما بیشترین شدت لنفوسیتهای آتیپیک بهطور کلاسیک در EBV دیده میشود.
ترومبوسیتوپنی خفیف با پلاکت ۵۰٬۰۰۰ تا ۲۰۰٬۰۰۰/µL در بیش از ۵۰٪ بیماران رخ میدهد، اما به ندرت با پورپورا همراه است.
افزایش خفیف ترانسآمینازهای کبدی (AST/ALT) در حدود ۷۵٪ موارد بدون عارضه دیده میشود؛ معمولاً بیعلامت است و بدون یرقان.
2) شناسایی آنتیبادیهای هتروفیل (Heterophile) — مثل Monospot
آنتیبادیهای هتروفیل، IgMهای cross-reactive هستند که گلبول قرمز پستانداران را آگلوتینه میکنند ولی اختصاصی EBV نیستند.
تستهای هتروفیل (مثل Monospot) در نوجوانان و بزرگسالان با مونونوکلئوز EBV:
در هفته دوم بیماری در حدود ۹۰٪ موارد مثبت میشوند.
در کودکان <۴ سال: حساسیت پایینتر است و حداکثر تا ۵۰٪ مثبت میشود.
نتیجه تست میتواند تا ۱۲ ماه مثبت باقی بماند.
نرخ مثبت کاذب پایین است، معمولاً <۱۰٪.
برداشت بالینی:
اگر بیمار تظاهرات کلاسیک مونونوکلئوز داشته باشد، هتروفیل مثبت بهشدت از تشخیص حمایت میکند.
اما چون غیراختصاصی است، وقتی تشخیص دقیق لازم باشد باید سرولوژی اختصاصی EBV انجام شود.
3) آنتیبادیهای اختصاصی EBV (EBV-specific serology)
اگر هتروفیل منفی باشد ولی به EBV شک داریم، باید سرولوژی اختصاصی انجام شود. شایعترین اهداف:
VCA (Viral Capsid Antigen)
EBNA (Epstein–Barr Nuclear Antigen)
EA (Early Antigen)
الگوی فاز حاد مونونوکلئوز:
در همه موارد: پاسخ سریع IgM و IgG علیه VCA
در اکثر موارد: IgG علیه EA
جزئیات زمانی:
Anti-VCA IgM: گذراست؛ معمولاً حداقل ۴ هفته قابل تشخیص و گاهی تا ۳ ماه؛ به ندرت طولانیتر.
Anti-VCA IgG: اواخر فاز حاد به اوج میرسد، سپس کمی کاهش یافته و بعد تا آخر عمر پایدار میماند.
Anti-EA IgG: معمولاً چند ماه مثبت میماند، اما ممکن است سالها باقی بماند یا متناوب با سطح پایین دیده شود.
اجزای EA:
EA-D (diffuse): در ۸۰٪ بیماران در فاز حاد بهطور گذرا دیده میشود.
EA-R (restricted): بهطور گذرا در دوره نقاهت ظاهر میشود.
سطح بالای EA-D یا EA-R میتواند در ایمونوساپرس/ایمونودفیشنسی با عفونت پایدار و تکثیر فعال EBV هم دیده شود.
Anti-EBNA IgG:
آخرین آنتیبادی است که ظاهر میشود: معمولاً ۳–۴ ماه پس از شروع بیماری.
سپس در سطح پایین تا پایان عمر باقی میماند.
نبود EBNA در حضور سایر آنتیبادیها ⇒ عفونت اخیر
وجود EBNA ⇒ عفونت مربوط به بیش از ۳–۴ ماه قبل
نکته کلیدی: معمولاً IgM ضد VCA برای تأیید عفونت حاد EBV کافی است، هرچند گاهی مثبت کاذب ممکن است رخ دهد.
4) تشخیص DNA ویروس (PCR / Viral load)
EBV DNA با Real-time PCR در:
خون کامل
PBMCs (سلولهای تکهستهای خون محیطی)
پلاسما
قابل شناسایی و کمیسازی است.
الگو:
در مونونوکلئوز، EBV DNA در PBMC و پلاسما برای مدتی کوتاه پس از شروع علائم دیده میشود و در PBMC ممکن است طولانیتر باقی بماند.
در بیماران ایمنوکامپتنت با تابلوی تیپیک معمولاً برای تشخیص لازم نیست.
کاربرد مهم:
پس از پیوند عضو جامد یا پیوند سلولهای بنیادی خونساز، اندازهگیری سریال viral loadبرای پایش PTLD (اختلال لنفوپرولیفراتیو پس از پیوند) استفاده میشود.
viral load بسیار بالا یا افزایش پیشرونده ⇒ خطر بالاتر PTLD (ولی تشخیص قطعی معمولاً با بیوپسی بافتی است).
برنامه پایش به زمان بعد از پیوند و فاکتورهای خطر (نوع پیوند، شدت ایمونوساپرشن) بستگی دارد.
برای پایش پاسخ درمان PTLD نیز مفید است.
همچنین برای غربالگری/پیشآگهی برخی بدخیمیهای مرتبط با EBV مثل:
کارسینوم نازوفارنکس
لنفوم هوچکین
به کار میرود.
نکات طلایی بوردی (High-yield)
CBC: لکوسیتوز 10–20k با لنفوسیت غالب + آتیپیک 20–40٪ (در EBV کلاسیکاً بیشترین)
پلاکت: ترومبوسیتوپنی خفیف شایع، پورپورا نادر
کبد: AST/ALT خفیف بالا در ۷۵٪، معمولاً بدون یرقان
Monospot:
نوجوان/بزرگسال هفته دوم: ~۹۰٪ مثبت
کودک <۴ سال: ≤۵۰٪
تا ۱۲ ماه ممکن است مثبت بماند
Serology:VCA IgM = نشانگر فاز حاد؛ EBNA IgG دیررس (۳–۴ ماه) و مادامالعمر
PCR: برای مونونوکلئوز تیپیک در فرد سالم معمولاً لازم نیست؛ پایش PTLD بعد از پیوند کاربرد کلیدی دارد.
پاورقی اصطلاحات مهم (Glossary)
Leukocytosis (لکوسیتوز): افزایش تعداد WBC.
Atypical lymphocytes (لنفوسیت آتیپیک): لنفوسیتهای فعالشده (در EBV عمدتاً T بالغ فعالشده).
Nuclear-to-cytoplasm ratio (نسبت هسته به سیتوپلاسم): معیار مورفولوژیک؛ در آتیپیکها کمتر میشود.
Thrombocytopenia (ترومبوسیتوپنی): کاهش پلاکت.
Purpura (پورپورا): لکه/خونریزی پوستی ناشی از خونریزی زیرجلدی.
Hepatic transaminases (ترانسآمینازهای کبدی): AST/ALT؛ نشانگر التهاب/آسیب کبدی.
Heterophile antibodies (آنتیبادی هتروفیل): IgMهای cross-reactive، غیراختصاصی EBV، پایه تست Monospot.
Monospot test (مونواسپات): تست هتروفیل برای مونونوکلئوز.
VCA (Viral Capsid Antigen): آنتیژن کپسید ویروس؛ VCA IgM نشانگر حاد.
EA (Early Antigen): آنتیژن زودرس؛ شامل EA-D و EA-R.
EBNA (Epstein–Barr Nuclear Antigen): آنتیژن هستهای؛ دیررس و مادامالعمر.
PBMCs: سلولهای تکهستهای خون محیطی (لنفوسیتها و مونوسیتها).
Real-time PCR / Viral load (PCR کمی/بار ویروسی): سنجش DNA و میزان نسخههای ژنومی.
PTLD: اختلال لنفوپرولیفراتیو پس از پیوند؛ مرتبط با EBV در زمینه ایمونوساپرشن.
درمان (Infectious Mononucleosis / EBV) — ترجمه فارسی با نکات برجسته
برای مونونوکلئوز عفونی درمان اختصاصی وجود ندارد. ارکان اصلی مدیریت عبارتاند از استراحت، مصرف کافی مایعات و تغذیه مناسب و درمان علامتی برای کنترل تب، ناراحتی گلو و بیحالی/کسالت.
استراحت مطلق (Bed rest) فقط زمانی لازم است که بیمار خستگی ناتوانکننده داشته باشد.
به محض اینکه بهبود واضح علائم ایجاد شد، باید بیمار را تشویق کرد که به فعالیتهای طبیعی برگردد.
چون ضربهی بلانت شکم میتواند زمینهساز پارگی طحال شود، بهطور معمول و منطقی توصیه میشود بیمار از ورزشهای تماسی و فعالیتهای شدید بدنی در ۲–۳ هفتهی اول بیماری یا تا وقتی اسپلنومگالی وجود دارد پرهیز کند.
داروهای ضدویروس
درمان ضدویروسی توصیه نمیشود.
اگرچه آنالوگهای نوکلئوزیدی مانند آسیکلوویر و گانسیکلوویر در شرایط آزمایشگاهی تکثیر ویروس را مهار میکنند و مدت دفع ویروس از ناحیه اوروفارنکس را در بیماران مبتلا کاهش میدهند، اما نشان داده نشده که بهطور مداوم باعث بهبود بالینی قابل اتکا در مونونوکلئوز عفونی یا بدخیمیهای مرتبط با EBV شوند.
کورتیکواستروئیدها
دورههای کوتاه کورتیکواستروئید ممکن است برای برخی عوارض انتخابی مونونوکلئوز عفونی مفید باشد؛ مثل انسداد راه هوایی.
اما شواهد کافی برای استفاده از کورتون جهت کنترل علائم معمول/تیپیک (مثل گلودرد و تب و بیحالی) در مونونوکلئوز وجود ندارد.
ایمونوتراپی adoptive (برای موارد خاص)
ایمونوتراپی adoptive شامل تزریق لنفوسیتهای T سیتوتوکسیک اختصاصی EBV در مطالعات اولیه، در گیرندگان پیوند مبتلا به PTLD و نیز برخی بیماران با بدخیمیهای مرتبط با EBV نتایج امیدوارکنندهای نشان داده است.
نکات کلیدی (High-yield)
درمان اختصاصی ندارد → مدیریت حمایتی و علامتی
Bed rest فقط در خستگی ناتوانکننده
بازگشت به فعالیت با بهبود علائم
پرهیز از ورزش تماسی/شدید: ۲–۳ هفته اول یا تا زمان اسپلنومگالی (بهعلت خطر پارگی طحال)
آنتیویروسها (acyclovir/ganciclovir): کاهش shedding، اما فایده بالینی ثابتشده ندارد → توصیه نمیشود
کورتون: فقط در عوارض منتخب مثل انسداد راه هوایی؛ نه برای علائم روتین
EBV-specific CTL infusion: گزینه امیدوارکننده در PTLD پس از پیوند/برخی بدخیمیهای EBV
پاورقی اصطلاحات مهم
Supportive/Symptomatic treatment (درمان حمایتی/علامتی): درمانی برای کاهش علائم بدون هدفگیری مستقیم عامل بیماری.
Malaise (بیحالی/کسالت): احساس ناخوشی عمومی و خستگی.
Blunt abdominal trauma (ضربه بلانت شکم): ضربه غیرنافذ به شکم (مثل برخورد در ورزش).
Splenic rupture (پارگی طحال): عارضه خطرناک، مرتبط با طحال بزرگشده در EBV.
Splenomegaly (اسپلنومگالی): بزرگ شدن طحال.
Contact sports (ورزشهای تماسی): ورزشهایی با احتمال ضربه مستقیم (فوتبال، کشتی، بسکتبال و…).
Oropharyngeal viral shedding (دفع ویروس از اوروفارنکس): خروج ویروس در ترشحات حلق/دهان.
Nucleoside analogs (آنالوگهای نوکلئوزیدی): داروهای ضدویروسی مثل acyclovir و ganciclovir.
Corticosteroids (کورتیکواستروئیدها): داروهای ضدالتهاب/ایمونوساپرس که در عوارض خاص ممکن است کمک کنند.
Airway obstruction (انسداد راه هوایی): تنگی/انسداد مسیر تنفسی، معمولاً بهعلت بزرگی بافتها/التهاب.
Adoptive immunotherapy (ایمونوتراپی adoptive): انتقال سلولهای ایمنی آماده (مثل CTL).
EBV-specific cytotoxic T lymphocytes (CTL اختصاصی EBV): لنفوسیتهای T کشنده که علیه سلولهای آلوده به EBV عمل میکنند.
PTLD: اختلال لنفوپرولیفراتیو پس از پیوند (Post-transplant lymphoproliferative disease).
سرطانزایی (Oncogenesis) — ترجمه فارسی با نکات برجسته
عفونت با EBV که اولین ویروس انسانی بود که ارتباطش با بدخیمی ثابت شد، در سطح جهانی مسئولِ تا حدود ۲٪ از کل سرطانها است (به جدول 301.1 مراجعه شود).
نکات مهم (High-yield)
EBV = اولین ویروس انسانی مرتبط با بدخیمی
بار جهانی بدخیمیهای مرتبط با EBV: تا ۲٪ از کل سرطانها
پاورقی اصطلاحات مهم
Oncogenesis (سرطانزایی): فرایندی که طی آن تغییرات سلولی و مولکولی منجر به ایجاد سرطان میشود.
Malignancy (بدخیمی): رشد کنترلنشده سلولها با توانایی تهاجم و گاهی متاستاز.
EBV (Epstein–Barr Virus): ویروس اپشتین–بار؛ یکی از هرپسویروسها با ارتباط شناختهشده با برخی بدخیمیها.
EBV-associated cancers (سرطانهای مرتبط با EBV): گروهی از بدخیمیها که در پاتوژنز آنها EBV نقش دارد (جزئیات معمولاً در جدول/فصل مربوطه میآید)
دستکاری سلولهای آلوده توسط EBV میتواند به ترنسفورماسیون (Transformation) و سرطانزایی (Oncogenesis) منجر شود.
EBV با بدخیمیهای لنفوئیدی مانند
- لنفوم بورکیت (Burkitt lymphoma)،
- لنفوم هوچکین (Hodgkin lymphoma)،
- لوسمی تهاجمی سلولهای NK،
- اختلال لنفوپرولیفراتیو سلولهای T و NK و
- بدخیمیهای اپیتلیالی مانند کارسینوم نازوفارنکس و کارسینوم معده ارتباط دارد.
1) لنفوم بورکیت اندمیک (Endemic Burkitt lymphoma)
بورکیت اندمیک شایعترین سرطان دوران کودکی در شرق استوایی آفریقا و پاپوا گینه نو است. این مناطق از نظر مالاریای Plasmodium falciparum بهصورت هولوآندمیک هستند و در آنها عفونت EBV در اوایل زندگی بسیار شایع است.
قرارگیری مداوم در معرض مالاریا احتمالاً:
بهعنوان یک میتوژن لنفوسیت B عمل میکند و به تکثیر پلیکلونال لنفوسیتهای B در زمینه عفونت EBV کمک میکند،
نظارت ایمنی لنفوسیتهای T روی لنفوسیتهای B آلوده به EBV را مختل میکند،
و در نهایت خطر بروز لنفوم بورکیت را افزایش میدهد.
حدود۹۸٪ موارد بورکیت اندمیک دارای ژنوم EBV هستند، در حالیکه در بورکیت غیراندِمیک/اسپورادیک در سایر مناطق جهان این نسبت فقط حدود ۲۰٪ است.
2) لنفوم هوچکین (Hodgkin lymphoma)
بروز هوچکین:
در کشورهای در حال توسعه در کودکی به اوج میرسد،
و در کشورهای توسعهیافته در اوایل بزرگسالی بیشترین است.
عفونت EBV خطر هوچکین را حدود ۲ تا ۴ برابر افزایش میدهد و اوج خطر ابتلا به هوچکین حدود ۲٫۴ سال پس از مونونوکلئوز عفونی رخ میدهد.
ارتباط EBV با زیرگروهها:
در بیش از نصف موارد Mixed-cellularity Hodgkin lymphoma مرتبط است،
در حدود یکچهارم موارد Nodular sclerosing subtype مرتبط است،
اما بهندرت با Lymphocyte-predominant Hodgkin lymphoma همراه است.
مطالعات ایمونوهیستوشیمی، EBV را در سلولهای رید–استرنبرگ (Reed–Sternberg) و واریانتهای آنها (سلولهای بدخیم شاخص و پاتوگنومونیک هوچکین) موضعیابی کردهاند.
3) نقص ایمنیها و لنفوپرولیفراسیون مرتبط با EBV
سندرمهای متعدد نقص ایمنی مادرزادی و اکتسابی با افزایش بروز لنفومهای سلول B مرتبط با EBV همراهاند؛ بهویژه:
لنفوم سیستم عصبی مرکزی (CNS lymphoma)
لِیومیوسارکوم (leiomyosarcoma)
نقصهای ایمنی مادرزادی مستعدکننده لنفوپرولیفراسیون EBV
XLP syndrome
CVID (نقص ایمنی متغیر شایع)
Ataxia-telangiectasia
Wiskott–Aldrich syndrome
Chédiak–Higashi syndrome
نقصهای ایمنی اکتسابی
افرادی که به علت:
شیمیدرمانی ضدسرطان
ایمونوساپرشن پس از پیوند عضو جامد یا پیوند سلولهای بنیادی خونساز
یا عفونت HIV
دچار نقص ایمنی هستند، خطر لنفوپرولیفراسیون مرتبط با EBV در آنها بهطور قابل توجهی افزایش مییابد.
ویژگیهای لنفومها در این زمینه:
میتوانند موضعی یا منتشر باشند،
غالباً از نظر بافتشناسی پلیکلونال هستند، اما ممکن است به سمت مونوکلونال شدن پیش بروند.
4) PTLD مرتبط با EBV
PTLD مرتبط با EBV میتواند پس از پیوند عضو جامد و (کمتر) پس از پیوند آلوژنیک سلولهای بنیادی خونساز رخ دهد.
مهمترین عوامل خطر PTLD:
میزان/شدت سرکوب ایمنی لنفوسیتهای T
وضعیت سرولوژیک EBV گیرنده (Recipient EBV serostatus)
نکات مهم بوردی (High-yield)
EBV میتواند با ترنسفورماسیون سلولی ← سرطانزایی همراه شود.
بدخیمیهای مرتبط:
لنفوئیدی: بورکیت، هوچکین، لوسمی تهاجمی NK، اختلالات لنفوپرولیفراتیو T/NK
اپیتلیالی: نازوفارنکس، معده
بورکیت اندمیک: مالاریای P. falciparum + EBV زودرس → اختلال نظارت T و تکثیر B → افزایش خطر؛ EBV+ در ۹۸٪.
هوچکین: EBV خطر را ۲–۴ برابر ↑؛ اوج خطر ۲٫۴ سال بعد از IM؛ ارتباط قویتر با mixed-cellularity.
نقص ایمنیها (مادرزادی/اکتسابی) → افزایش لنفوپرولیفراسیون EBV، بهویژه CNS lymphoma.
PTLD: ریسک اصلی = شدت سرکوب T + سرواستاتوس EBV گیرنده.
پاورقی اصطلاحات مهم
Transformation (ترنسفورماسیون): تغییرات پایدار سلولی که به رشد/بقای غیرطبیعی و زمینهسازی بدخیمی منجر میشود.
Oncogenesis (سرطانزایی): روند ایجاد سرطان.
Lymphoid malignancy (بدخیمی لنفوئیدی): سرطانهایی با منشأ لنفوسیتها/سلولهای ایمنی.
Burkitt lymphoma (لنفوم بورکیت): لنفوم بسیار تهاجمی سلول B؛ نوع اندمیک به EBV قویتر مرتبط است.
Holoendemic malaria (مالاریای هولوآندمیک):
شیوع بسیار بالا و پایدار مالاریا در منطقه.
Mitogen (میتوژن): محرکی که تقسیم سلولی را افزایش میدهد (اینجا برای سلول B).